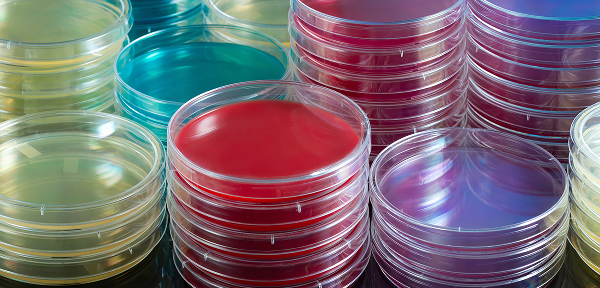
Agar plates colourful.png
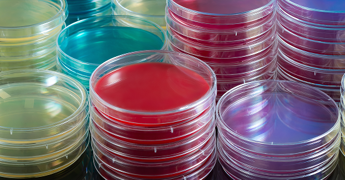
Agar plates colourful.png

Advanced technologies for reliable diagnostics
Trusted solutions for your market area needs

Looking for a specific product?
Lorem ipsum dolor sit amet, consectetur adipiscing elit, sed do eiusmod tempor incididunt ut labore et dolore magna aliqua.


Need help finding the right product?
Edi Lorem ipsum dolor sit amet, consectetur adipiscing elit, sed do eiusmod tempor incididunt ut labore et dolore magna aliqua.






